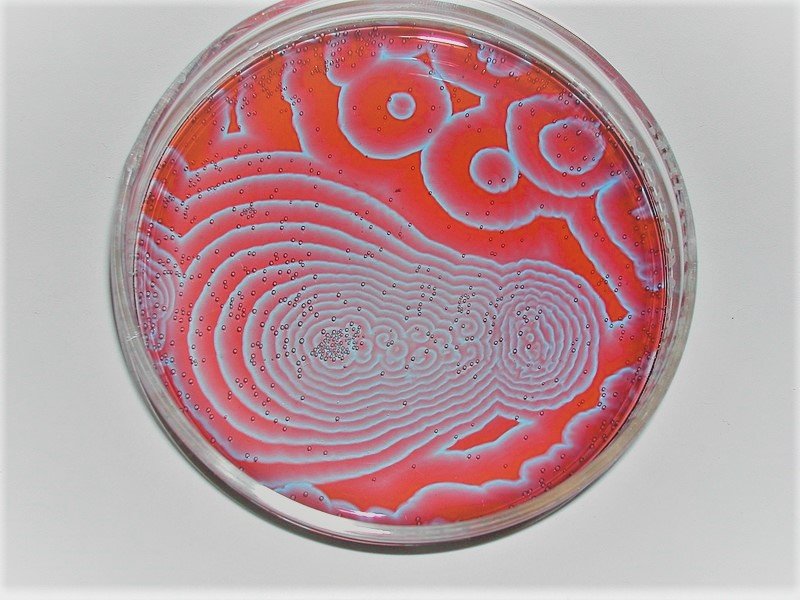

3 OF THE WEIRDEST ELEMENTS +MORE
- Kr/Krypton

This tasteless inert gas (they don’t react with other elements) is pretty rare to be found. It is present in trace amounts in the atmosphere and has 31 isotopes out of which only 5 are stable. It was discovered in 1898.
It can be used to detect secret nuclear weapon bases where the research/production of nuclear bombs may be carried out.
It also helped in establishing a definition for a meter, which was defined as the length of the wavelength of krypton-86 isotope
Even though it is referred to as a noble gas, it reacts only with Flourine; which is very desperate to react with something, so much so that it reacts with a noble gas!
2. BISMUTH

If there was an element which could be put up on this list solely on the basis of appearance, this would be the one.
Plus, here’s another cool fact about it;
Bismuth practices magic; for real.
Bismuth is repelled to magnetic fields. You might think, what’s interesting here?
Well, here’s what’s interesting;
IF you take 2 pieces of Bismuth and then place a magnet in between them, the magnet will start to levitate. Pure magic then!

3. OSMIUM

This is also the densest element on Earth and is 30 times more valuable than gold, while being harder than diamond. It is also one of the rarest elements on Earth with a density of 22.59 g/cm³. It is used in fountain pens and becomes shiny upon heating at first.
COOL REACTIONS
- BZ REACTION
This is the perfect chemical reaction to act as an optical illusion.
To perform this reaction, first you have to mix 4 chemicals, namely, Sodium Bromide (NaBr), Sodium Bromate (NaBrO3), Sulphuric Acid (H2SO4) and Malonic Acid (C3H4O4). Then, a colouring is to be added so as to get a view of what is happening in the reaction. After that, we have to pour it into a dish and wait for the reaction to happen. The reaction appears as if red dots are appearing from another red dot simultaneously.
2. LUMINOL

It is a molecule which grows upon reacting with substances like hydrogen peroxide, an then reacts with oxygen. To lower the energy it has, it emits light. It’s formula is C8H7N3O2.
3. RAINBOW FLAMES

This reaction can be performed individually and depends on the choice of the person who is doing the reaction whether to do it in a combined manner or individually.
To perform this reaction, we will perform the following steps:-
- Take 10 petridishes/borosilicate beakers
- Drop some Strontium Chloride (SrCl2) into the first beaker. Place a cotton ball in it. Pour in some ethyl alcohol to dampen the cotton ball.
- Drop Strontium Nitrate [Sr(NO3)2], Sodium Chloride (NaCl), Barium Chloride (BaCl2), Copper Nitrate [Cu(NO3)2], Potassium Nitrate (KNO3), Lithium Chloride (LiCl), Sodium Nitrate (NaNO3), Copper Chloride (CuCl2), Copper Sulfate (CuSO4) into other beakers. Place a cotton ball in the respective beakers. Make sure to pour in some ethyl alcohol in the beakers to dampen the cotton ball.
- Light them up and enjoy the reaction! (make sure to stay away to stay safe)
WHAT WILL HAPPEN IF WE MIX ALL THE ELEMENTS??

Simple Answer: The Earth Explodes
Detailed Answer: Most of the reactive elements will react with each other violently. Plus, Flourine, would actually REACT WITH LITERALLY EVERYTHING YOU HAVE with the exception of Helium, Neon and Argon. Not even the noble gases were spared in it’s urge to gain an electron.
Now, once the reaction is complete (which will be very,very violent) you will obtain quark-gluon plasma, which was the matter obtained right after the big bang. Quarks are present in the nucleus of atom (this is what the protons and neutrons are made up of). If we are able to heat our atoms enough (which in this case, is happening), the nucleons will melt and we will have quarks and a force called gluon between them just running around, which is a new state of matter known as quark gluon plasma.


